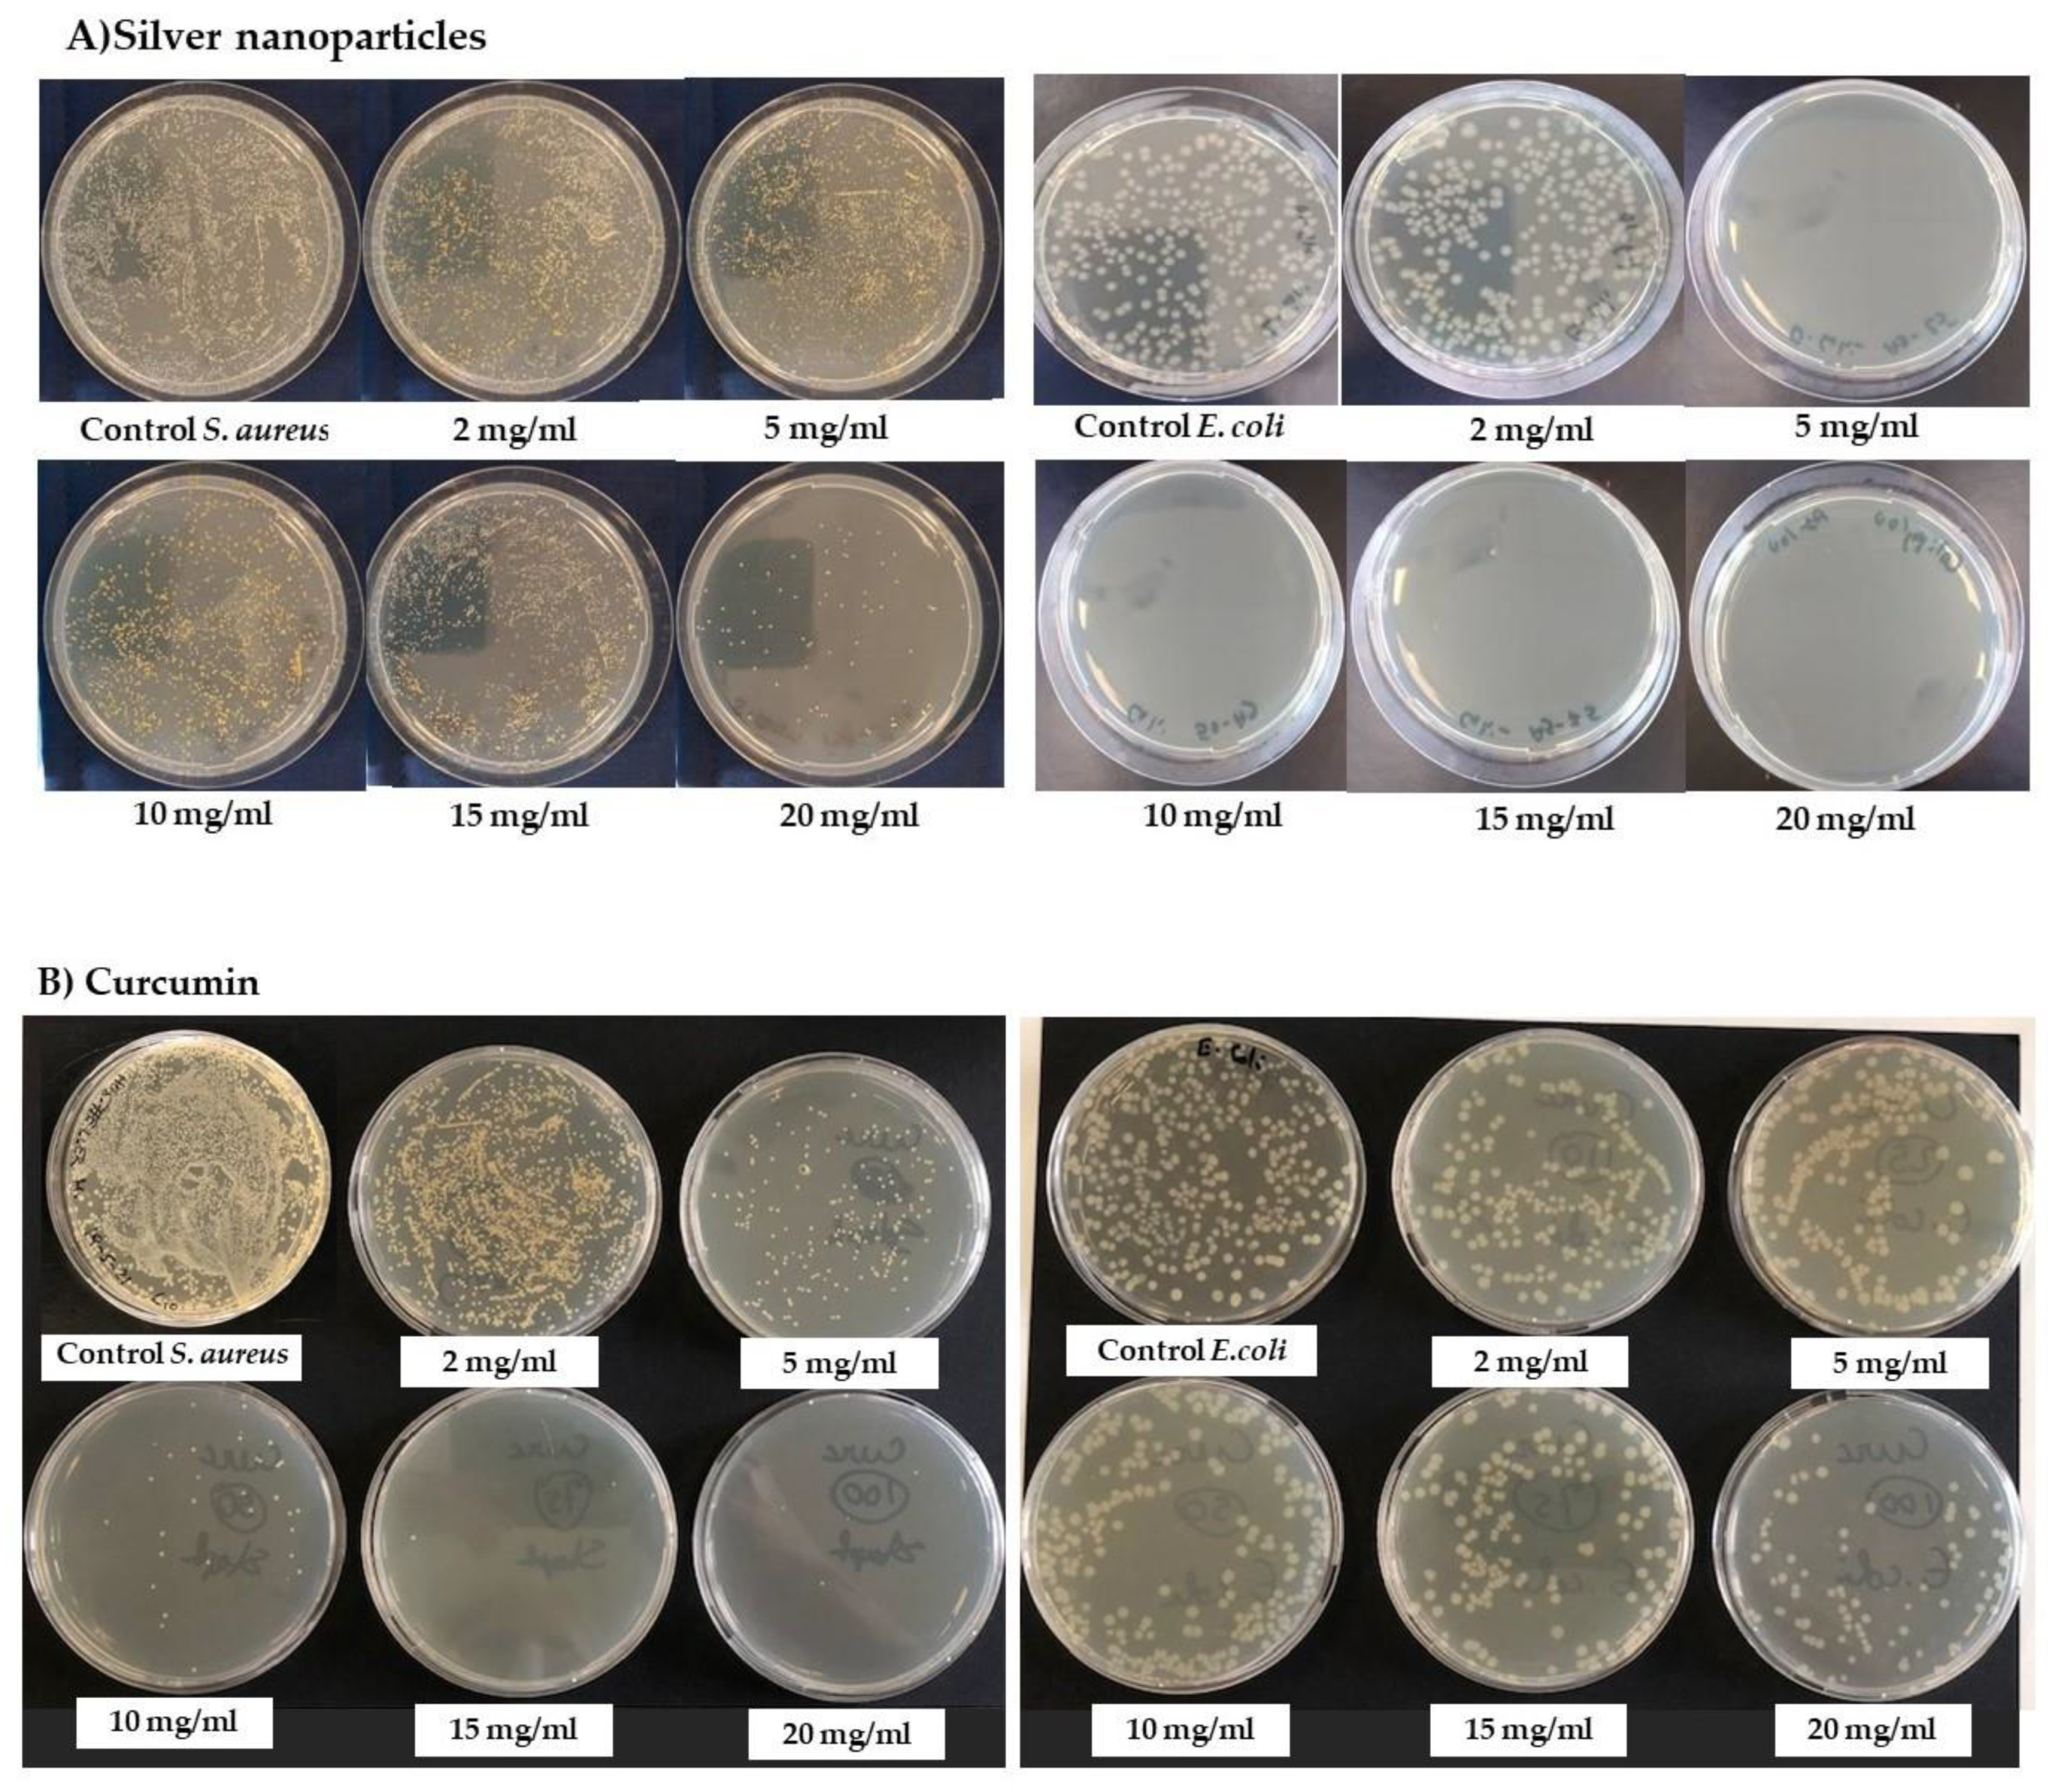
Nanomaterials 12 00283 g006 550

Curcumin and Silver Doping Enhance the Spinnability and Antibacterial Activity of Melt-Electrospun Polybutylene Succinate Fibers
Abstract
:1. Introduction
2. Materials and Methods
2.1. Materials
2.2. Micro-Compounder
2.3. Methods
2.3.1. Synthesis of Silver Nanoparticles
2.3.2. Melt-Electrospinning Equipment
2.3.3. Characterization of Materials and Compounds
2.3.4. Characterization of Fibers
2.3.5. Biological Activity
3. Results and Discussion
3.1. Material Analysis
3.1.1. Characterization of Silver Nanoparticles
3.1.2. Thermal Degradation of Materials Used
3.1.3. Thermal Properties of the Materials
3.1.4. Antibacterial Properties of the Active Materials
3.2. Compound Analysis
3.2.1. Thermal Analysis of the Compounds
3.2.2. Thermal Properties of the Compounds
3.2.3. Molecular Weight of the Compounds
3.2.4. Effect of the Additives on Viscosity
3.2.5. Effect of Additives on Electrical Conductivity
3.2.6. FTIR Spectroscopy
3.3. Fiber Analysis
3.3.1. Fiber Diameter and Distribution
3.3.2. Analysis of Fiber Morphology by SEM
3.3.3. Analysis of Fiber Properties by GPC
3.3.4. Antibacterial Activity of the Loaded Fibers
4. Conclusions
Author Contributions
Funding
Data Availability Statement
Acknowledgments
Conflicts of Interest
References
- Lee, S.; Kay Obendorf, S.K. Developing protective textile materials as barriers to liquid penetration using melt-electrospinning. J. Appl. Polym. Sci. 2006, 102, 3430–3437. [Google Scholar] [CrossRef]
- Shin, Y.M.; Hohman, M.M.; Brenner, M.P.; Rutledge, G.C. Electrospinning: A whipping fluid jet generates submicron polymer fibers. Appl. Phys. Lett. 2001, 78, 1149–1151. [Google Scholar] [CrossRef]
- Bhat, G.S. Advances in Polymeric Nanofiber Manufacturing Technologies. J. Nanomater. Mol. Nanotechnol. 2016, 5, 1–2. [Google Scholar] [CrossRef]
- Koenig, K.; Langensiepen, F.; Seide, G.; Daenicke, J.; Schubert, D. From Lab to Pilot Scale: Melt Electrospun Nanofibers of Polypropylene with Conductive Additives. J. Nanomater. Mol. Nanotechnol. 2018, 7, 1–8. [Google Scholar]
- Sundarrajan, S.; Tan, K.L.; Lim, S.H.; Ramakrishna, S. Electrospun Nanofibers for Air Filtration Applications. Procedia Eng. 2014, 75, 159–163. [Google Scholar] [CrossRef] [Green Version]
- Wang, J.; Li, Y.; Sun, X. Challenges and opportunities of nanostructured materials for aprotic rechargeable lithium–air batteries. Nano Energy 2013, 2, 443–467. [Google Scholar] [CrossRef]
- Wang, X.; Drew, C.; Lee, S.-H.; Senecal, K.J.; Kumar, J.; Samuelson, L.A. Electrospun Nanofibrous Membranes for Highly Sensitive Optical Sensors. Nano Lett. 2002, 2, 1273–1275. [Google Scholar] [CrossRef]
- Brown, T.D.; Dalton, P.D.; Hutmacher, D.W. Melt electrospinning today: An opportune time for an emerging polymer process. Prog. Polym. Sci. 2016, 56, 116–166. [Google Scholar] [CrossRef]
- Bhardwaj, N.; Kundu, S.C. Electrospinning: A fascinating fiber fabrication technique. Biotechnol. Adv. 2010, 28, 325–347. [Google Scholar] [CrossRef] [PubMed]
- Ogata, N.; Shimada, N.; Yamaguchi, S.; Nakane, K.; Ogihara, T. Melt-electrospinning of poly(ethylene terephthalate) and polyalirate. J. Appl. Polym. Sci. 2007, 105, 1127–1132. [Google Scholar] [CrossRef]
- Zaiss, S.; Brown, T.D.; Reichert, J.C.; Berner, A. Poly(epsilon-caprolactone) Scaffolds Fabricated by Melt Electrospinning for Bone Tissue Engineering. Materials 2016, 9, 232. [Google Scholar] [CrossRef] [PubMed] [Green Version]
- Jing, X.; Mi, H.-Y.; Salick, M.R.; Cordie, T.M.; Peng, X.-F.; Turng, L.-S. Electrospinning thermoplastic polyurethane/graphene oxide scaffolds for small diameter vascular graft applications. Mater. Sci. Eng. C 2015, 49, 40–50. [Google Scholar] [CrossRef] [PubMed]
- Ko, J.; Kan, D.; Jun, M.B. Combining melt electrospinning and particulate leaching for fabrication of porous microfibers. Manuf. Lett. 2015, 3, 5–8. [Google Scholar] [CrossRef]
- Hacker, C.; Seide, G.; Gries, T.; Thomas, H.; Moeller, M. Electrospinning of polymer melt: Steps toward an upscaled multi-jet process. In Proceedings of the International Conference Latest Advances in High Tech Textiles and Textile-Based Materials, Ghent, Belgium, 23–25 September 2009; pp. 71–76. [Google Scholar]
- Qin, Y.; Cheng, L.; Zhang, Y.; Chen, X.; Wang, X.; He, X.; Yang, W.; An, Y.; Li, H. Efficient preparation of poly(lactic acid) nanofibers by melt differential electrospinning with addition of acetyl tributyl citrate. J. Appl. Polym. Sci. 2018, 135, 46554. [Google Scholar] [CrossRef]
- Doustgani, A.; Ahmadi, E. Melt electrospinning process optimization of polylactic acid nanofibers. J. Ind. Text. 2016, 45, 626–634. [Google Scholar] [CrossRef]
- Ostheller, M.-E.; Balakrishnan, N.; Groten, R.; Seide, G. Detailed Process Analysis of Biobased Polybutylene Succinate Microfibers Produced by Laboratory-Scale Melt Electrospinning. Polymers 2021, 13, 1024. [Google Scholar] [CrossRef]
- Zhang, C.-L.; Yu, S.-H. Nanoparticles meet electrospinning: Recent advances and future prospects. Chem. Soc. Rev. 2014, 43, 4423–4448. [Google Scholar] [CrossRef]
- Krishnan, P.D.; Banas, D.; Durai, R.D.; Kabanov, D.; Hosnedlova, B.; Kepinska, M.; Fernandez, C.; Ruttkay-Nedecky, B.; Nguyen, H.V.; Farid, A.; et al. Silver Nanomaterials for Wound Dressing Applications. Pharmaceutics 2020, 12, 821. [Google Scholar] [CrossRef]
- Sadeghianmaryan, A.; Yazdanpanah, Z.; Soltani, Y.A.; Sardroud, H.A.; Nasirtabrizi, M.H.; Chen, X. Curcumin-loaded electrospun polycaprolactone/montmorillonite nanocomposite: Wound dressing application with anti-bacterial and low cell toxicity properties. J. Biomater. Sci. Polym. Ed. 2020, 31, 169–187. [Google Scholar] [CrossRef]
- Cai, N.; Zeng, H.; Fu, J.; Chan, V.; Chen, M.; Li, H.; Yu, F. Synergistic effect of graphene oxide-silver nanofillers on engineering performances of polyelectrolyte complex nanofiber membranes. J. Appl. Polym. Sci. 2018, 135, 46238. [Google Scholar] [CrossRef]
- Lutomski, J.; Kedzia, B.; Debska, W. Wirkung des aethanolextraktes und aktiver Substanzen aus Curcuma Longa auf Bakterien und Pilze. Planta Med. 1974, 26, 9–19. [Google Scholar] [CrossRef]
- Shlar, I.; Droby, S.; Choudhary, R.; Rodov, V. The mode of antimicrobial action of curcumin depends on the delivery system: Monolithic nanoparticles vs. supramolecular inclusion complex. RSC Adv. 2017, 7, 42559–42569. [Google Scholar] [CrossRef] [Green Version]
- Sambhy, V.; MacBride, M.M.; Peterson, B.R.; Sen, A. Silver Bromide Nanoparticle/Polymer Composites: Dual Action Tunable Antimicrobial Materials. J. Am. Chem. Soc. 2006, 128, 9798–9808. [Google Scholar] [CrossRef]
- Brett, D.W. A discussion of silver as an antimicrobial agent: Alleviating the confusion. Ostomy Wound Manag. 2006, 52, 34–41. [Google Scholar]
- Mitsubishi Chemical Corporation. Available online: https://www.m-chemical.co.jp/en/products/departments/mcc/sustainable/product/1201025_7964.html (accessed on 25 October 2021).
- Sigma Aldrich. Available online: https://www.sigmaaldrich.com/NL/en/product/sigma/c1386 (accessed on 25 October 2021).
- Abdelgawad, A.; El-Naggar, M.E.; Eisa, W.; Rojas, O.J. Clean and high-throughput production of silver nanoparticles mediated by soy protein via solid state synthesis. J. Clean. Prod. 2017, 144, 501–510. [Google Scholar] [CrossRef]
- Correlo, V.M.; Boesel, L.F.; Bhattacharya, M.; Mano, J.F.; Neves, N.M.; Reis, R.L. Properties of melt processed chitosan and aliphatic polyester blends. Mater. Sci. Eng. A 2005, 403, 57–68. [Google Scholar] [CrossRef] [Green Version]
- Pan, H.; Zhang, Y.; He, G.-X.; Katagori, N.; Chen, H. A comparison of conventional methods for the quantification of bacterial cells after exposure to metal oxide nanoparticles. BMC Microbiol. 2014, 14, 222. [Google Scholar] [CrossRef] [Green Version]
- Asoro, M.; Damiano, J.; Ferreira, P. Size Effects on the Melting Temperature of Silver Nanoparticles: In-Situ TEM Observations. Microsc. Microanal. 2009, 15, 706–707. [Google Scholar] [CrossRef] [Green Version]
- Bode, L.G.M.; Kluytmans, J.A.J.W.; Wertheim, H.F.L.; Bogaers, D.; Vandenbroucke-Grauls, C.M.J.E.; Roosendaal, R.; Troelstra, A.; Box, A.T.A.; Voss, A.; van der Tweel, I.; et al. Preventing surgical-site inf tions in nasal carriers of Staphylococcus aureus. N. Engl. J. Med. 2010, 362, 9–17. [Google Scholar] [CrossRef] [Green Version]
- Hegge, A.B.; Bruzell, E.; Kristensen, S.; Tonnesen, H.H. Photoinactivation of Staphylococcus epidermidis biofilms and suspensions by the hydrophobic photosensitizer curcumin—Effect of selected nanocarrier: Studies on curcumin and curcuminoides XLVII. Eur. J. Pharm. Sci. 2012, 47, 65–74. [Google Scholar] [CrossRef]
- Gurunathan, S.; Han, J.W.; Kwon, D.-N.; Kim, J.-H. Enhanced antibacterial and anti-biofilm activities of silver nanoparticles against Gram-negative and Gram-positive bacteria. Nanoscale Res. Lett. 2014, 9, 373. [Google Scholar] [CrossRef] [Green Version]
- Zhan, J.; Chen, Y.; Tang, G.; Pan, H.; Zhang, Q.; Song, L.; Hu, Y. Crystallization and melting properties of poly(butylene succinate) composites with titanium dioxide nanotubes or hydroxyapatite nanorods. J. Appl. Polym. Sci. 2014, 131, 1–10. [Google Scholar] [CrossRef]
- Marcilla, A.; Beltrán, M. Mechanisms of Plasticizers Action. In Handbook of Plasticizers; Wypych, G., Ed.; William Andrew Publishing: Boston, MA, USA, 2012; pp. 119–133. [Google Scholar]
- Esatbeyoglu, T.; Ulbrich, K.; Rehberg, C.; Rohn, S.; Rimbach, G. Thermal stability, antioxidant, and anti-inflammatory activity of curcumin and its degradation product 4-vinyl guaiacol. Food Funct. 2015, 6, 887–893. [Google Scholar] [CrossRef] [PubMed] [Green Version]
- Rahamathullah, R.; Khairul, W.M.; Bulat, K.K.; Hussin, Z. Influence of curcumin as a natural photosensitizer in the conductive thin film of alkoxy cinnamoyl substituted thiourea. Main Group Chem. 2015, 14, 185–198. [Google Scholar] [CrossRef]
- Phua, Y.J.; Chow, W.S.; Mohd Ishak, Z.A. The hydrolytic effect of moisture and hygrothermal aging on poly(butylene succinate)/organo-montmorillonite nanocomposites. Polym. Degrad. Stab. 2011, 96, 1194–1203. [Google Scholar] [CrossRef]
- Mayerhoefen, T.G. Modelling IR-spectra of single-phase polycrystallne materials with random orientation—A unified approach. Vib. Spectrosc. 2004, 35, 67–76. [Google Scholar] [CrossRef]
- Laroui, H.; Wilson, D.S.; Dalmasso, G.; Salaita, K.; Murthy, N.; Sitaraman, S.V.; Merlin, D. Nanomedicine in GI. Am. J. Physiol.-Gastrointest. Liver Physiol. 2011, 300, G371–G383. [Google Scholar] [CrossRef]
- Tian, L.; Wang, P.; Zhao, Z.; Ji, J. Antimicrobial Activity of Electrospun Poly(butylenes succinate) Fiber Mats Containing PVP-Capped Silver Nanoparticles. Appl. Biochem. Biotechnol. 2013, 171, 1890–1899. [Google Scholar] [CrossRef]

| Material | Chemical Structure | Melting Point (°C) |
|---|---|---|
| PBS | ![]() | 115 °C |
| Curcumin | ![]() | 175 °C |
| Compound Abbreviation | Additive | Percentage of Additive (w/w) |
|---|---|---|
| C1 | Curcumin | 1 |
| C3 | Curcumin | 3 |
| C5 | Curcumin | 5 |
| C7 | Curcumin | 7 |
| C10 | Curcumin | 10 |
| S1 | Silver nanoparticles | 1 |
| S3 | Silver nanoparticles | 3 |
| S5 | Silver nanoparticles | 5 |
| S7 | Silver nanoparticles | 7 |
| S10 | Silver nanoparticles | 10 |
| Material | Residual Weight before Isothermal (235 °C) (%) | Residual Weight after Isothermal (%) | 50% Weight Loss Temperature |
|---|---|---|---|
| PBS | 99.50% | 97.76% | 398.00 °C |
| Curcumin | 99.14% | 91.00% | 389.10 °C |
| Silver before calcination | 89.67% | 76.53% | 383.37 °C |
| Silver after calcination | 97.58% | 96.97% | - |
| Material | Residual Weight until 235 °C (%) | Residual Weight after Isothermal (%) | 50% Weight Loss Temperature |
|---|---|---|---|
| PBS | 99.85% | 98,15% | 356.00 °C |
| C1 | 99.64% | 98.55% | 364.34 °C |
| C3 | 99.67% | 98.57% | 365.83 °C |
| C5 | 99.70% | 98.69% | 364.60 °C |
| C7 | 99.67% | 98.48% | 366.75 °C |
| C10 | 99.66% | 98.01% | 366.51 °C |
| S1 | 99.62% | 96.63% | 358.92 °C |
| S3 | 99.56% | 97.83% | 361.07 °C |
| S5 | 99.45% | 97.85% | 360.44 °C |
| S7 | 99.46% | 98.11% | 362.78 °C |
| S10 | 98.74% | 98.19% | 360.66 °C |
| Material | Tm1 (°C) | Tm2 (°C) | Trc (°C) | Tc (°C) | Xc (%) |
|---|---|---|---|---|---|
| PBS | 112.41 ± 1 | 96.95 ± 2 | 74.41 ± 1 | 55.42 ± 1 | |
| C1 | 107.89 ± 2 | 112.46 ± 1 | 98.25 ± 1 | 74.78 ± 1 | 55.44 ± 1 |
| C3 | 106.89 ± 2 | 112.15 ± 1 | 96.26 ± 2 | 73.24 ± 1 | 56.41 ± 1 |
| C5 | 105.88 ± 1 | 111.71 ± 1 | 94.29 ± 3 | 71.55 ± 3 | 57.37 ± 2 |
| C7 | 105.54 ± 1 | 111.19 ± 1 | 92.63 ± 2 | 69.62 ± 3 | 58.60 ± 2 |
| C10 | 104.53 ± 1 | 110.73 ± 2 | 91.50 ± 3 | 68.07 ± 3 | 59.24 ± 2 |
| S1 | - | 112.16 ± 1 | 98.15 ± 2 | 76.04 ± 2 | 55.48 ± 1 |
| S3 | - | 112.12 ± 1 | 99.26 ± 2 | 78.36 ± 3 | 55.63 ± 1 |
| S5 | - | 111.95 ± 1 | 95.57 ± 3 | 73.42 ± 1 | 55.80 ± 1 |
| S7 | - | 111.87 ± 1 | 96.07 ± 2 | 73.41 ± 1 | 56.06 ± 2 |
| S10 | - | 111.60 ± 1 | 95.26 ± 3 | 72.36 ± 1 | 55.08 ± 1 |
Publisher’s Note: MDPI stays neutral with regard to jurisdictional claims in published maps and institutional affiliations. |
© 2022 by the authors. Licensee MDPI, Basel, Switzerland. This article is an open access article distributed under the terms and conditions of the Creative Commons Attribution (CC BY) license (https://creativecommons.org/licenses/by/4.0/).
Share and Cite
Ostheller, M.-E.; Abdelgawad, A.M.; Balakrishnan, N.K.; Hassanin, A.H.; Groten, R.; Seide, G. Curcumin and Silver Doping Enhance the Spinnability and Antibacterial Activity of Melt-Electrospun Polybutylene Succinate Fibers. Nanomaterials 2022, 12, 283. https://doi.org/10.3390/nano12020283
Ostheller M-E, Abdelgawad AM, Balakrishnan NK, Hassanin AH, Groten R, Seide G. Curcumin and Silver Doping Enhance the Spinnability and Antibacterial Activity of Melt-Electrospun Polybutylene Succinate Fibers. Nanomaterials. 2022; 12(2):283. https://doi.org/10.3390/nano12020283
Chicago/Turabian StyleOstheller, Maike-Elisa, Abdelrahman M. Abdelgawad, Naveen Kumar Balakrishnan, Ahmed H. Hassanin, Robert Groten, and Gunnar Seide. 2022. "Curcumin and Silver Doping Enhance the Spinnability and Antibacterial Activity of Melt-Electrospun Polybutylene Succinate Fibers" Nanomaterials 12, no. 2: 283. https://doi.org/10.3390/nano12020283
APA StyleOstheller, M.-E., Abdelgawad, A. M., Balakrishnan, N. K., Hassanin, A. H., Groten, R., & Seide, G. (2022). Curcumin and Silver Doping Enhance the Spinnability and Antibacterial Activity of Melt-Electrospun Polybutylene Succinate Fibers. Nanomaterials, 12(2), 283. https://doi.org/10.3390/nano12020283



